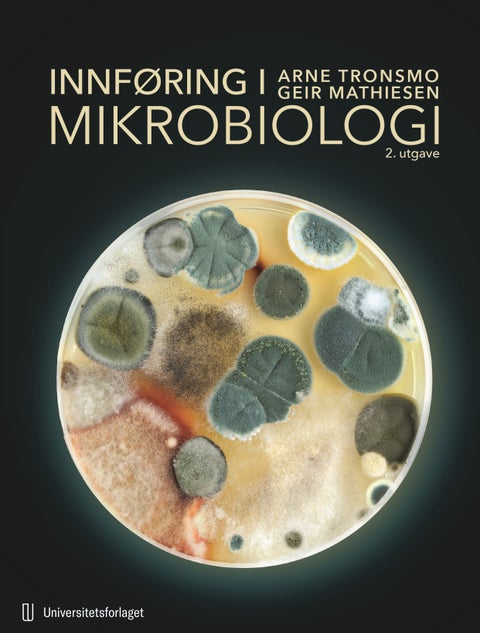
Innføring i mikrobiologi

- Bøker
- Spill og puslespill
- Leker
- Babyleker
- Dukker, bamser og figurer
- Lego
- Uteleker
- Hobby og kreativitet
- Topplister leker
- Lekebiler og togbaner
- Lekebiler og togbaner
- Utkledning og sminke
- Utkledning og sminke
- Småleker og actionleker
- Småleker og actionleker
- Populære merker
- Babyleker
- Sekker og skolesaker
- Skolesekker
- Barnehagesekker
- Gymbag
- Matbokser og drikkeflasker
- Matbokser og drikkeflasker
- Pennaler
- Skolemateriell
- Tilbehør
- Papir og kontor
- Tegne og male
- Gaver, interiør og reise
- Inspirasjon
- Tilbud
- Gavekort
Favoritter
Geir Mathiesen
Bøker skrevet av Geir Mathiesen
1 resultater